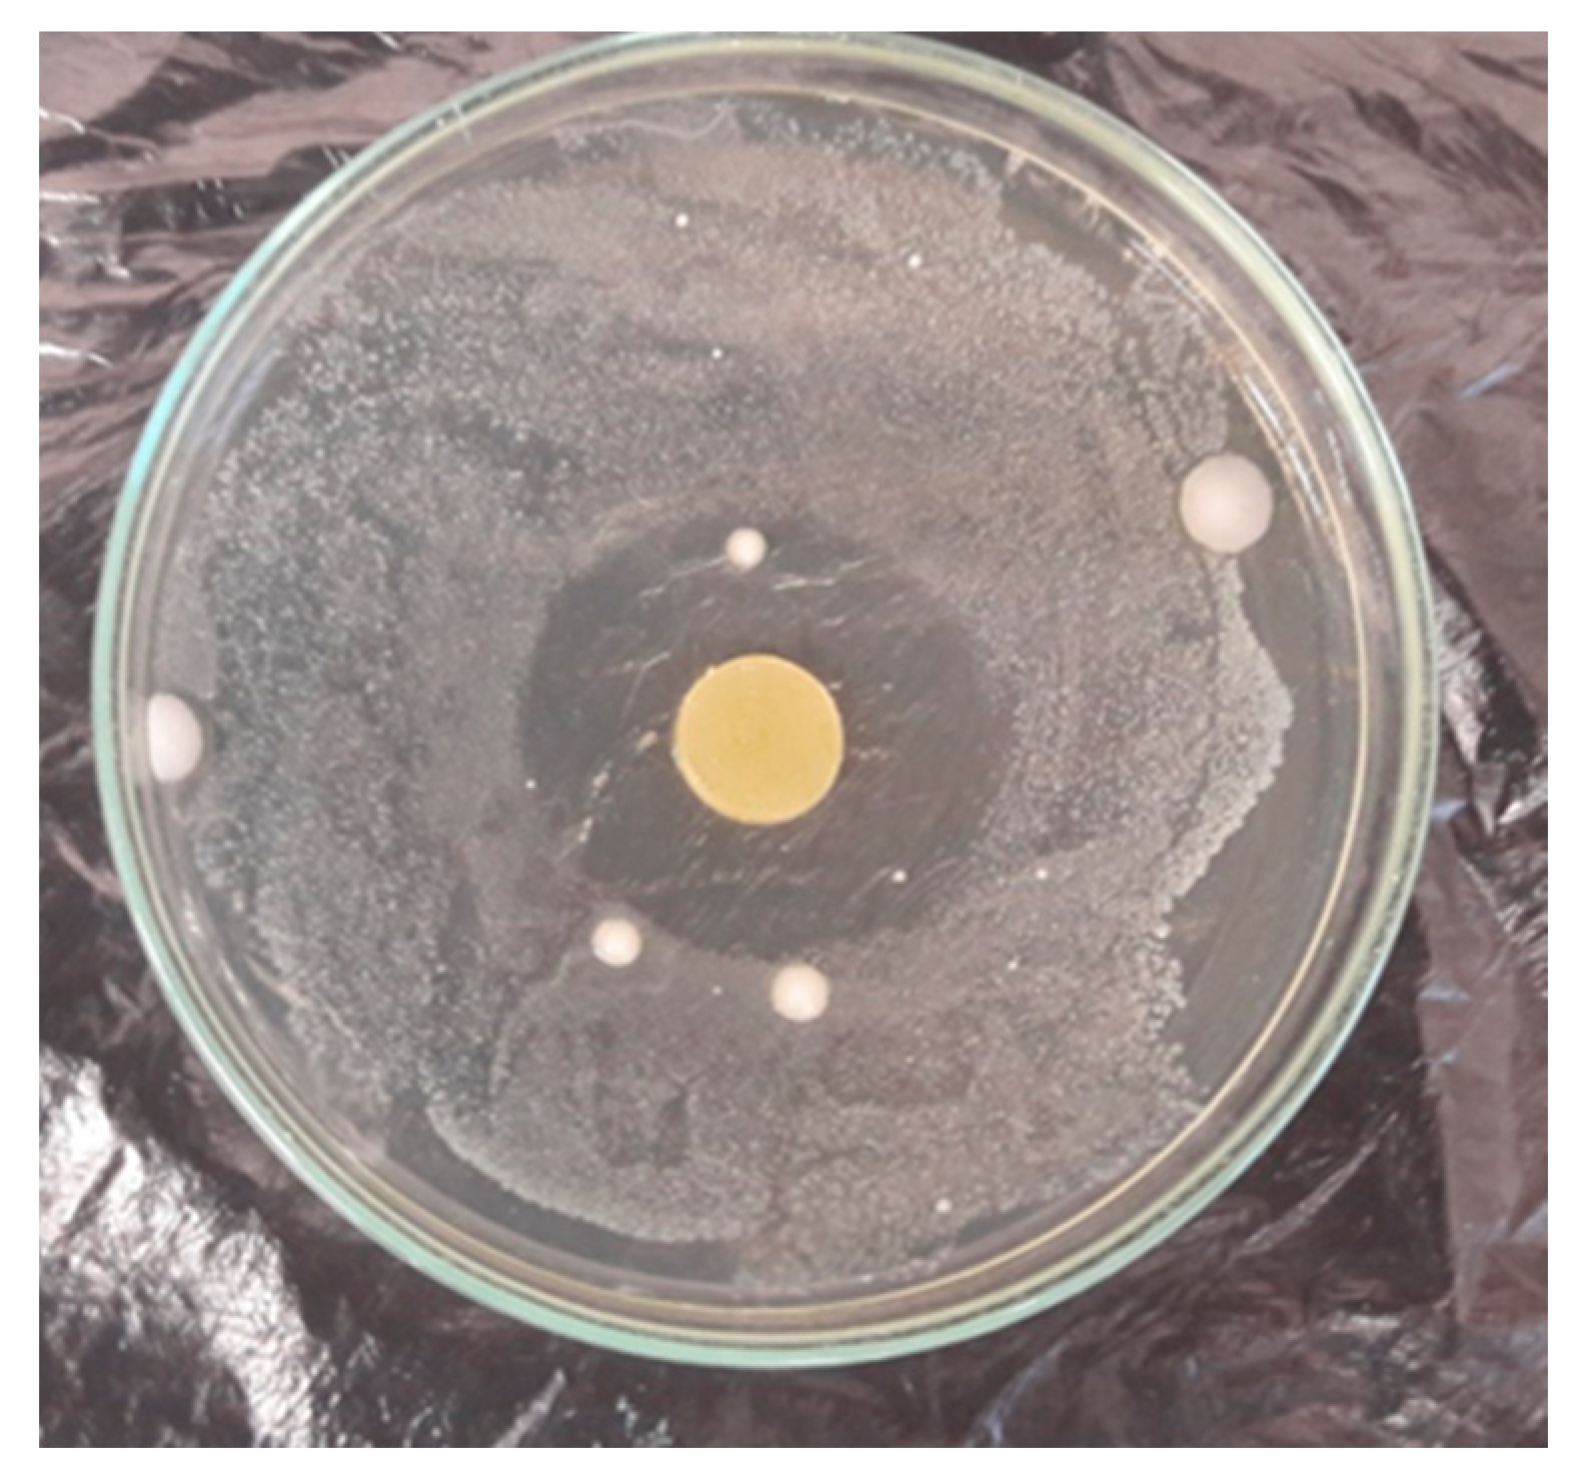
Materials 16 02698 g010 Materials 16 02698 g010

Modification of Poly(vinyl chloride) with Bio-Based Cassia Oil to Improve Thermo-Mechanical and Antimicrobial Properties
Abstract
1. Introduction
2. Materials and Methods
2.1. Materials
2.2. Sample Preparation
2.3. Material Characterizations
2.3.1. Determination of Processability
2.3.2. Determination of Rheological Properties
2.3.3. Determination of Mechanical Properties
2.3.4. Determination of the Glass Transition Temperature
2.3.5. Fourier-Transform Infrared Spectroscopy (FTIR) Analysis
2.3.6. Determination of Thermal Properties by Thermogravimetric Analysis
2.3.7. Determination of Antioxidant Activity
2.3.8. Determination of the Antimicrobial Activity
3. Results
3.1. Determination of Processability and Rheological Characteristics
3.2. Mechanical Analysis
3.3. Thermomechanical Analysis DMA and Tg Determination
3.4. Thermogravimetric Analysis by TGA Method
3.5. FTIR Analysis
3.6. Antioxidant Activity
3.7. Antimicrobial Activity
4. Conclusions
Author Contributions
Funding
Institutional Review Board Statement
Data Availability Statement
Conflicts of Interest
References
- Srisa, A.; Promhuad, K.; San, H.; Laorenza, Y.; Wongphan, P.; Wadaugsorn, K.; Sodsai, J.; Kaewpetch, T.; Tansin, K.; Harnkarnsujarit, N. Antibacterial, Antifungal and Antiviral Polymeric Food Packaging in Post-COVID-19 Era. Polymers 2022, 14, 4042. [Google Scholar] [CrossRef] [PubMed]
- Pandey, S.; Sharma, K.; Gundabala, V. Antimicrobial bio-inspired active packaging materials for shelf life and safety development: A review. Food Biosci. 2022, 48, 101730. [Google Scholar] [CrossRef]
- Singh, M.; Singh, R.K.; Singh, S.K.; Mahto, S.K.; Misra, N. In vitro biocompatibility analysis of functionalized poly(vinyl chloride)/layered double hydroxide nanocomposites. RSC Adv. 2018, 8, 40611–40620. [Google Scholar] [CrossRef] [PubMed]
- Summers, J.W. A review of vinyl technology. J. Vinyl Addit. Technol. 1997, 3, 130–139. [Google Scholar] [CrossRef]
- Czogała, J.; Pankalla, E.; Turczyn, R. Recent Attempts in the Design of Efficient PVC Plasticizers with Reduced Migration. Materials 2021, 14, 844. [Google Scholar] [CrossRef]
- Lewandowski, M.; Piszczek, K.; Pienkowska, M.; Lewandowski, K. Innovative oligomeric poly(vinyl chloride) plasticizers for specialized applications. Polimery 2020, 65, 550–556. [Google Scholar] [CrossRef]
- Asadinezhad, A.; Novák, I.; Lehocký, M.; Sedlařík, V.; Vesel, A.; Junkar, I.; Sáha, P.; Chodák, I. A Physicochemical Approach to Render Antibacterial Surfaces on Plasma-Treated Medical-Grade PVC: Irgasan Coating. Plasma Process. Polym. 2010, 7, 504–514. [Google Scholar] [CrossRef]
- Braga, L.R.; Pérez, L.M.; Soazo, M.D.V.; Machado, F. Evaluation of the antimicrobial, antioxidant and physicochemical properties of Poly(Vinyl chloride) films containing quercetin and silver nanoparticles. LWT Food Sci. Technol. 2019, 101, 491–498. [Google Scholar] [CrossRef]
- Villanueva, M.E.; González, J.A.; Rodríguez-Castellón, E.; Teves, S.; Copello, G.J. Antimicrobial surface functionalization of PVC by a guanidine based antimicrobial polymer. Mater. Sci. Eng. C 2016, 67, 214–220. [Google Scholar] [CrossRef]
- Zhang, M.; Li, D.; Dong, T.; Hou, X.; Zhang, X.; Liu, H.; Liu, L.; Tang, S.; Liu, S. Improving antibacterial, biocompatible, and reusable properties of polyvinyl chloride via the addition of aluminum alkoxides. J. Vinyl Addit. Technol. 2021, 27, 519–532. [Google Scholar] [CrossRef]
- Gniewosz, M.; Stobnicka, A. Comparison of antimicrobial activity of manuka (Leptospermun scoparium) and kanuka (Kunzea ericoides) essential oils. Bromatol. Chem. Toksykol. 2012, 3, 639–644. [Google Scholar]
- Nabavi, S.M.; Di Lorenzo, A.; Izadi, M.; Sobarzo-Sánchez, E.; Daglia, M.; Nabavi, S. Antibacterial Effects of Cinnamon: From Farm to Food, Cosmetic and Pharmaceutical Industries. Nutrients 2015, 7, 7729–7748. [Google Scholar] [CrossRef] [PubMed]
- Oun, A.A.; Shin, G.H.; Rhim, J.-W.; Kim, J.T. Recent advances in polyvinyl alcohol-based composite films and their applications in food packaging. Food Packag. Shelf Life 2022, 34, 100991. [Google Scholar] [CrossRef]
- Chacha, J.S.; Ofoedu, C.E.; Xiao, K. Essential Oil-Based Active Polymer-Based Packaging System: A Review of Its Effect on the Antimicrobial, Antioxidant, and Sensory Properties of Beef and Chicken Meat. J. Food Process Preserv. 2022, 46, e16933. [Google Scholar] [CrossRef]
- Min, T.; Zhou, L.; Sun, X.; Du, H.; Zhu, Z.; Wen, Y. Electrospun functional polymeric nanofibers for active food packaging: A review. Food Chem. 2022, 391, 133239. [Google Scholar] [CrossRef]
- Szulc, J.; Lewandowski, K.; Skórczewska, K.; Sadkiewicz, J. Release of thymol from plasticized poly(vinyl chloride). Polimery 2018, 63, 825–829. [Google Scholar] [CrossRef]
- Lin, D.; Wu, Z.; Huang, Y.; Wu, J.; Li, C.; Qin, W.; Wu, D.; Li, S.; Chen, H.; Zhang, Q. Physical, Mechanical, Structural and Antibacterial Properties of Polyvinyl Alcohol/Oregano Oil/Graphene Oxide Composite Films. J. Polym. Environ. 2020, 28, 638–646. [Google Scholar] [CrossRef]
- Campini, P.A.L.; de Oliveira, R.; Camani, P.H.; da Silva, C.G.; Yudice, E.D.C.; de Oliveira, S.A.; Rosa, D.D.S. Assessing the efficiency of essential oil and active compounds/poly (lactic acid) microcapsules against common foodborne pathogens. Int. J. Biol. Macromol. 2021, 186, 702–713. [Google Scholar] [CrossRef]
- Barbosa, R.F.D.S.; Yudice, E.D.C.; Mitra, S.K.; Rosa, D.D.S. Characterization of Rosewood and Cinnamon Cassia essential oil polymeric capsules: Stability, loading efficiency, release rate and antimicrobial properties. Food Control 2021, 121, 107605. [Google Scholar] [CrossRef]
- Wen, P.; Zhu, D.-H.; Wu, H.; Zong, M.-H.; Jing, Y.-R.; Han, S.-Y. Encapsulation of cinnamon essential oil in electrospun nanofibrous film for active food packaging. Food Control 2016, 59, 366–376. [Google Scholar] [CrossRef]
- Zhang, W.; Shu, C.; Chen, Q.; Cao, J.; Jiang, W. The multi-layer film system improved the release and retention properties of cinnamon essential oil and its application as coating in inhibition to penicillium expansion of apple fruit. Food Chem. 2019, 299, 125109. [Google Scholar] [CrossRef]
- Srisa, A.; Harnkarnsujarit, N. Antifungal films from trans-cinnamaldehyde incorporated poly(lactic acid) and poly(butylene adipate-co-terephthalate) for bread packaging. Food Chem. 2020, 333, 127537. [Google Scholar] [CrossRef]
- Rajput, C.V.; Mukherjee, R.B.; Sastry, N.V.; Chikhaliya, N.P. Epoxidized Cassia fistula Seed Oil as Bio-Based Plasticizer for Poly(vinyl chloride) Soft Films. ACS Appl. Polym. Mater. 2022, 4, 8926–8941. [Google Scholar] [CrossRef]
- Subramanian, K.; Vadivu, K.S.; Subramaniyam, L.; Kumar, M.D. Synthesis, characterization, and analysis of bioplasticizer derived from Hibiscus rosa-sinensis leaves and cinnamon bark for poly (vinyl chloride) films. Ind. Crops Prod. 2022, 182, 114933. [Google Scholar] [CrossRef]
- Arrieta, M.P.; Samper, M.D.; Jiménez-López, M.; Aldás, M.; Lopez, J. Combined effect of linseed oil and gum rosin as natural additives for PVC. Ind. Crops Prod. 2017, 99, 196–204. [Google Scholar] [CrossRef]
- Omer, A.M.; Tamer, T.M.; El Monem, A.; Elmoaty, S.A.; El Fatah, M.A.; Saad, G.R. Development of PVC membranes with clove oil as plasticizer for blood bag applications. J. Appl. Pharm. Sci. 2016, 6, 85–93. [Google Scholar] [CrossRef]
- Alves de Figueiredo Sousa, H.; Gonçalves de Oliveira Filho, J.; Egea, M.B.; Rosa da Silva, E.; Macagnan, D.; Pires, M.; Peixoto, J. Active film incorporated with clove essential oil on storage of banana varieties. Nutr. Food Sci. 2019, 49, 911–924. [Google Scholar] [CrossRef]
- Da Silva, C.F.; De Oliveira, F.S.M.; Caetano, V.F.; Vinhas, G.M.; Cardoso, S.A. Orange essential oil as antimicrobial additives in poly(vinyl chloride) films. Polímeros 2018, 28, 332–338. [Google Scholar] [CrossRef]
- Nejatian, M.; Ghandehari Yazdi, A.P.; Khorasani, S.; Simal-Gandara, J. Increasing the shelf life of fresh in-hull pistachio using nanocomposite packaging of zinc nanoparticles and pistachio green hull essential oil. Sci. Hortic. 2023, 313, 111888. [Google Scholar] [CrossRef]
- Amina, M.; Al Musayeib, N.M.; Alarfaj, N.A.; El-Tohamy, M.F.; Orabi, H.E.; Bukhari, S.I.; Mahmoud, A.Z. Exploiting the Potential of Moringa oleifera Oil/Polyvinyl Chloride Polymeric Bionanocomposite Film Enriched with Silver Nanoparticles for Antimicrobial Activity. Int. J. Polym. Sci. 2019, 2019, 5678149. [Google Scholar] [CrossRef]
- Ribeiro-Santos, R.; Andrade, M.; de Melo, N.R.; dos Santos, F.R.; Neves, I.D.A.; de Carvalho, M.G.; Sanches-Silva, A. Biological activities and major components determination in essential oils intended for a biodegradable food packaging. Ind. Crops Prod. 2017, 97, 201–210. [Google Scholar] [CrossRef]
- Ma, Y.; Li, L.; Wang, Y. Development of antimicrobial active film containing CINnamaldehyde and its application to snakehead (Ophiocephalus argus) fish. J. Food Process. Eng. 2017, 40, e12554. [Google Scholar] [CrossRef]
- Ribeiro-Santos, R.; Sanches-Silva, A.; Motta, J.F.G.; Andrade, M.; Neves, I.D.A.; Teófilo, R.F.; de Carvalho, M.G.; de Melo, N.R. Combined use of essential oils applied to protein base active food packaging: Study in vitro and in a food simulant. Eur. Polym. J. 2017, 93, 75–86. [Google Scholar] [CrossRef]
- Kerosenewala, J.; Vaidya, P.; Ozarkar, V.; Shirapure, Y.; More, A.P. Eugenol: Extraction, Properties and Its Applications on Incorporation with Polymers and Resins—A Review. Polym. Bull. 2022, 2022, 1–53. [Google Scholar] [CrossRef]
- Fan, S.; Wang, D.; Wen, X.; Li, X.; Fang, F.; Richel, A.; Xiao, N.; Fauconnier, M.-L.; Hou, C.; Zhang, D. Incorporation of cinnamon essential oil-loaded Pickering emulsion for improving antimicrobial properties and control release of chitosan/gelatin films. Food Hydrocoll. 2023, 138, 108438. [Google Scholar] [CrossRef]
- Adilah, Z.M.; Lyn, F.H.; Nabilah, B.; Jamilah, B.; Hean, C.G.; Hanani, Z.N. Enhancing the physicochemical and functional properties of gelatin/graphene oxide/cinnamon bark oil nanocomposite packaging films using ferulic acid. Food Packag. Shelf Life 2022, 34, 100960. [Google Scholar] [CrossRef]
- Mehta, M.J.; Kumar, A. Green and Efficient Processing of Cinnamomum cassia Bark by Using Ionic Liquids: Extraction of Essential Oil and Construction of UV-Resistant Composite Films from Residual Biomass. Chem. Asian J. 2017, 12, 3150–3155. [Google Scholar] [CrossRef]
- Wang, R.; Wang, R.; Yang, B. Extraction of essential oils from five cinnamon leaves and identification of their volatile compound compositions. Innov. Food Sci. Emerg. Technol. 2009, 10, 289–292. [Google Scholar] [CrossRef]
- Ooi, L.S.M.; Li, Y.; Kam, S.-L.; Wang, H.; Wong, E.Y.L.; Ooi, V.E.C. Antimicrobial Activities of Cinnamon Oil and Cinnamaldehyde from the Chinese Medicinal Herb Cinnamomum cassia Blume. Am. J. Chin. Med. 2006, 34, 511–522. [Google Scholar] [CrossRef]
- Zachariah, T.J.; Leela, N.K. Volatiles from Herbs and Spices. In Handbook of Herbs and Spices; Elsevier: Amsterdam, The Netherlands, 2006; Volume 3, pp. 177–218. ISBN 9781845691714. [Google Scholar]
- Klozinski, A.; Barczewski, M. Comparison of off-line, on-line and in-line measuring techniques used for determining the rheological characteristics of polyethylene composites with calcium carbonate. Polimery 2021, 64, 83–92. [Google Scholar] [CrossRef]
- Klozinski, A.; Sterzynski, T. Evaluation of correction factors in rheological investigations of polyethylene. Part II. Power low index, Rabinowitsch correction. Polimery 2007, 52, 855–862. [Google Scholar] [CrossRef]
- Lewandowski, K.; Piszczek, K.; Zajchowski, S.; Mirowski, J. Rheological properties of wood polymer composites at high shear rates. Polym. Test. 2016, 51, 58–62. [Google Scholar] [CrossRef]
- Ferry, J.D. Viscoelastic Properties of Polymers, 3rd ed.; John Wiley and Sons: New York, NY, USA, 1980; ISBN 9780471048947. [Google Scholar]
- Skórczewska, K.; Lewandowski, K.; Szewczykowski, P.; Wilczewski, S.; Szulc, J.; Stopa, P.; Nowakowska, P. Waste Eggshells as a Natural Filler for the Poly(Vinyl Chloride) Composites. Polymers 2022, 14, 4372. [Google Scholar] [CrossRef] [PubMed]
- Brand-Williams, W.; Cuvelier, M.E.; Berset, C. Use of a free radical method to evaluate antioxidant activity. LWT Food Sci. Technol. 1995, 28, 25–30. [Google Scholar] [CrossRef]
- Makarewicz, E. Physicomechanical and structural properties of plasticized poly(vinyl chloride) Właściwości fizykomechaniczne i strukturalne plastyfikowanego poli(chlorku winylu). Przemysł. Chem. 2017, 1, 222–227. [Google Scholar] [CrossRef]
- Shnawa, H.A. Characterization of processing, rheological and dynamic mechanical thermal properties of PVC stabilized with polyphenol-based thermal stabilizer. J. Therm. Anal. Calorim. 2020, 139, 125–135. [Google Scholar] [CrossRef]
- Piszczek, K. Gelation of Suspension, Unplastified poly(vinyl chloride) Wydaw; Uczelniane Uniwersytetu Technologiczno-Przyrodniczego: Bydgoszcz, Poland, 2009. [Google Scholar]
- Lewandowski, K.; Skorczewska, K.; Piszczek, K.; Manikowski, M.; Mirowski, J. Modification of rigid poly(vinyl chloride) for application in three-layer feed pipes. Polimery 2020, 65, 304–310. [Google Scholar] [CrossRef]
- Feng, K.; Wen, P.; Yang, H.; Li, N.; Lou, W.Y.; Zong, M.H.; Wu, H. Enhancement of the antimicrobial activity of cinnamon essential oil-loaded electrospun nanofilm by the incorporation of lysozyme. RSC Adv. 2017, 7, 1572–1580. [Google Scholar] [CrossRef]
- Tomaszewska, J.; Sterzyński, T.; Walczak, D. Thermal Stability of Nanosilica-Modified Poly(vinyl chloride). Polymers 2021, 13, 2057. [Google Scholar] [CrossRef]
- Iván, B. The stability of poly(vinyl chloride). J. Vinyl Addit. Technol. 2003, 9, 1–3. [Google Scholar] [CrossRef]
- Hejna, A.; Barczewski, M.; Kosmela, P.; Mysiukiewicz, O. Mandarin peel as an auspicious functional filler. Maced. J. Chem. Chem. Eng. 2021, 40, 89–106. [Google Scholar] [CrossRef]
- Boughendjioua, H.; Amoura, N.; Boughendjioua, Z. Purity Specifications of Constituents of Cinnamon Essential Oil by Fourier Transformed Infrared Spectroscopy Analysis. Indian J. Pharm. Biol. Res. 2017, 5, 36–40. [Google Scholar] [CrossRef]
- Yaseen, A.A.; Yousif, E.; Al-Tikrity, E.T.B.; El-Hiti, G.A.; Kariuki, B.M.; Ahmed, D.S.; Bufaroosha, M. FTIR, Weight, and Surface Morphology of Poly(vinyl chloride) Doped with Tin Complexes Containing Aromatic and Heterocyclic Moieties. Polymers 2021, 13, 3264. [Google Scholar] [CrossRef]
- Acik, G. Bio-based Poly(ɛ-caprolactone) from Soybean-Oil Derived Polyol via Ring-Opening Polymerization. J. Polym. Environ. 2020, 28, 668–675. [Google Scholar] [CrossRef]
- Tee, Y.B.; Talib, R.A.; Abdan, K.; Chin, N.L.; Basha, R.K.; Yunos, K.F. Comparative Study of Chemical, Mechanical, Thermal, and Barrier Properties of Poly(Lactic Acid) Plasticized with Epoxidized Soybean Oil and Epoxidized Palm Oil. Bioresources 2015, 11, 1518–1540. [Google Scholar] [CrossRef]
- Liu, K.; Liu, Y.; Chen, F. Effect of storage temperature on lipid oxidation and changes in nutrient contents in peanuts. Food Sci. Nutr. 2019, 7, 2280–2290. [Google Scholar] [CrossRef]
- Zdanowska-Sąsiadek, Ż.; Damaziak, K.; Marchewka, J.; Horbańczuk, O.K.; Jóźwiak, A.; Wójcik, W.; Ławiński, M.; Wójcik, A.; Horbańczuk, J.O. Lipid- and Protein Oxidation during Storage and in Vitro Gastrointestinal Digestion of Ostrich, Beef and Chicken Jerky Snacks. Anim. Sci. Pap. Rep. 2022, 40, 305–316. [Google Scholar]
- Kim, S.A.; Rhee, M.S. Highly enhanced bactericidal effects of medium chain fatty acids (caprylic, capric, and lauric acid) combined with edible plant essential oils (carvacrol, eugenol, β-resorcylic acid, trans -cinnamaldehyde, thymol, and vanillin) against Escherichia coli O157:H7. Food Control 2016, 60, 447–454. [Google Scholar] [CrossRef]
- Diego, A.; Melo, B.; Amaral, A.F.; Schaefer, G.; Luciano, F.B.; de Andrade, C.; Costa, L.B.; Rostagno, M.H. Antimicrobial Effect against Different Bacterial Strains and Bacterial Adaptation to Essential Oils Used as Feed Additives Résumé. Can. J. Vet. Res. 2015, 79, 285–289. [Google Scholar]
- Abers, M.; Schroeder, S.; Goelz, L.; Sulser, A.; Rose, T.S.; Puchalski, K.; Langland, J. Antimicrobial activity of the volatile substances from essential oils. BMC Complement. Med. Ther. 2021, 3, 124. [Google Scholar] [CrossRef]
- Tajkarimi, M.M.; Ibrahim, S.A.; Cliver, D.O. Antimicrobial herb and spice compounds in food. Food Control 2010, 21, 1199–1218. [Google Scholar] [CrossRef]
- Berthold-Pluta, A.; Stasiak-Różańska, L.; Pluta, A.; Garbowska, M. Antibacterial activities of plant-derived compounds and essential oils against Cronobacter strains. Eur. Food Res. Technol. 2019, 245, 1137–1147. [Google Scholar] [CrossRef]
- Souza, A.C.; Goto, G.E.O.; Mainardi, J.A.; Coelho, A.C.V.; Tadini, C.C. Cassava starch composite films incorporated with cinnamon essential oil: Antimicrobial activity, microstructure, mechanical and barrier properties. LWT Food Sci. Technol. 2013, 54, 346–352. [Google Scholar] [CrossRef]
- Kim, H.-K.; Yun, Y.-K.; Ahn, Y.-J. Fumigant toxicity of cassia bark and cassia and cinnamon oil compounds to Dermatophagoides farinae and Dermatophagoides pteronyssinus (Acari: Pyroglyphidae). Exp. Appl. Acarol. 2008, 44, 1–9. [Google Scholar] [CrossRef] [PubMed]
- Pateiro, M.; Munekata, P.E.S.; Sant, A.S.; Rodríguez-l, D.; Lorenzo, M. I Application of Essential Oils as Antimicrobial Agents against Spoilage and Pathogenic Microorganisms in Meat Products. Int. J. Food Microbiol. 2021, 337, 108966. [Google Scholar] [CrossRef]

| Material | Kneading Time | |||||
|---|---|---|---|---|---|---|
| 2 min | 10 min | 20 min | ||||
| M, Nm | T, °C | M, Nm | T, °C | M, Nm | T, °C | |
| PVC 50ES | 12.2 | 137.0 | 11.0 | 153.0 | 10.1 | 155.0 |
| PVC 50ES 1CO | 11.9 | 142.2 | 10.3 | 153.9 | 9.5 | 155.0 |
| PVC 50ES 5CO | 11.6 | 142.7 | 9.2 | 153.4 | 8.6 | 154.1 |
| PVC 50ES 10CO | 10.3 | 142.7 | 8.3 | 151.4 | 7.6 | 152.1 |
| PVC 50ES 20CO | 8.3 | 140.9 | 6.2 | 149.4 | 5.4 | 150.1 |
| Material | Tg, °C | Max E″, °C | Max tan δ, °C | E′, MPa | ||
|---|---|---|---|---|---|---|
| −25 °C | 0 °C | 25 °C | ||||
| PVC 50ES | −25.7 | −2.1 | 36.9 | 3433 | 1867 | 411 |
| PVC 50ES 1CO | −29.1 | −8.9 | 31.8 | 3288 | 1431 | 264 |
| PVC 50ES 5CO | −36.1 | −13.7 | 25.3 | 3039 | 1073 | 160 |
| PVC 50ES 10CO | −44.0 | −19.2 | 17.9 | 2790 | 759 | 86 |
| PVC 50ES 20CO | −51.9 | −33.0 | 6.6 | 1551 | 204 | 37 |
| Material | T1, °C | T5, °C | T50, °C | TDTG1, °C | Mass Loss 30–180 °C, % | TDTG2, °C | TDTG3, °C | RM at 900 °C, % |
|---|---|---|---|---|---|---|---|---|
| PVC 50ES | 262.3 | 264.4 | 315.8 | - | 0.1 | 263.5 | 292.7 | 11.1 |
| PVC 50ES 1CO | 260.6 | 264.5 | 316.3 | - | 0.5 | 262.9 | 292.6 | 10.8 |
| PVC 50ES 5CO | 177.5 | 262.1 | 313.5 | 167.8 | 2.8 | 262.6 | 292.7 | 10.8 |
| PVC 50ES 10CO | 153.9 | 260.4 | 310.6 | 169.2 | 4.9 | 261.9 | 293.1 | 10.8 |
| PVC 50ES 20CO | 132.5 | 190.1 | 303.5 | 169.9 | 9.9 | 261.3 | 293.0 | 10.2 |
| Material | Migration, mg/g | |
|---|---|---|
| 7 Days | 30 Days | |
| PVC 50ES 1CO | 0.17 | 3.73 |
| PVC 50ES 5CO | 4.62 | 8.33 |
| PVC 50ES 10CO | 10.19 | 17.74 |
| PVC 50ES 20CO | 12.23 | 38.57 |
| Material | Antioxidant Activity during the Storage, % | ||
|---|---|---|---|
| 0 Days | 10 Days | 30 Days | |
| PVC 50ES | 23 bB | 28 aD | 31 aC |
| PVC 50ES 1CO | 29 cB | 41 bC | 47 aB |
| PVC 50ES 5CO | 29 bB | 42 aC | 49 aB |
| PVC 50ES 10CO | 44 bA | 50 aB | 53 aB |
| PVC 50ES 20CO | 40 cA | 59 bA | 74 aA |
| Material | Bacterial Inhibition Zone Width, mm: | |
|---|---|---|
| Enterococcus Faecalis | Listeria monocytogenes | |
| PVC 50ES | 0 | 0 |
| PVC 50ES 1CO | 0 | 3.0 |
| PVC 50ES 5CO | 1.0 | 8.0 |
| PVC 50ES 10CO | 2.0 | 11.0 |
| PVC 50ES 20CO | 1.0 | 9.0 |
Disclaimer/Publisher’s Note: The statements, opinions and data contained in all publications are solely those of the individual author(s) and contributor(s) and not of MDPI and/or the editor(s). MDPI and/or the editor(s) disclaim responsibility for any injury to people or property resulting from any ideas, methods, instructions or products referred to in the content. |
© 2023 by the authors. Licensee MDPI, Basel, Switzerland. This article is an open access article distributed under the terms and conditions of the Creative Commons Attribution (CC BY) license (https://creativecommons.org/licenses/by/4.0/).
Share and Cite
Skórczewska, K.; Szulc, J.; Lewandowski, K.; Ligocka, A.; Wilczewski, S. Modification of Poly(vinyl chloride) with Bio-Based Cassia Oil to Improve Thermo-Mechanical and Antimicrobial Properties. Materials 2023, 16, 2698. https://doi.org/10.3390/ma16072698
Skórczewska K, Szulc J, Lewandowski K, Ligocka A, Wilczewski S. Modification of Poly(vinyl chloride) with Bio-Based Cassia Oil to Improve Thermo-Mechanical and Antimicrobial Properties. Materials. 2023; 16(7):2698. https://doi.org/10.3390/ma16072698
Chicago/Turabian StyleSkórczewska, Katarzyna, Joanna Szulc, Krzysztof Lewandowski, Anna Ligocka, and Sławomir Wilczewski. 2023. "Modification of Poly(vinyl chloride) with Bio-Based Cassia Oil to Improve Thermo-Mechanical and Antimicrobial Properties" Materials 16, no. 7: 2698. https://doi.org/10.3390/ma16072698
APA StyleSkórczewska, K., Szulc, J., Lewandowski, K., Ligocka, A., & Wilczewski, S. (2023). Modification of Poly(vinyl chloride) with Bio-Based Cassia Oil to Improve Thermo-Mechanical and Antimicrobial Properties. Materials, 16(7), 2698. https://doi.org/10.3390/ma16072698

